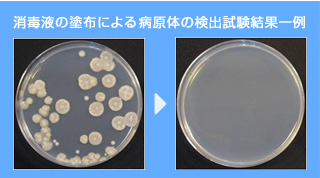
消毒液の塗布による病原体の検出試験結果一例

what_main
 English
English

車両消毒装置の設置には法律(家畜伝染予防法)による設置義務の他に、地域社会や同業、そして自社のためにも設置する必要があります。
以下では車両消毒装置の設置の目的と対象とする病原体について記載します。

 家畜伝染予防法への対応
家畜伝染予防法への対応
2011年10月1日、家畜の伝染性疾病の発生を予防し、及びまん延を防止することにより、畜産の振興を図るために、家畜伝染予防法施行規則等の一部を改正・施行され、家畜の所有者は消毒装置を設置する義務が課されました。
消毒設備の設置等の義務
各伝染予防法第 8条の2
- 政令で定め家畜の所有者は、農林水産省令の定めるところにより、舎その他の農林水産省令で定める施設及びその敷地(農林水産省令で定める敷地を除く。)の出入口付近に、特定疾病又は監視伝染病の発生を予防するために必要な消毒をする設備を設置しなければならない。
- 前項の設備が設置されている同項の施設に入る者は、農林水産省令の定めるところにより、あらかじめ、当該設備を利用して、自らその身体を消毒するとともに、当該施設に持ち込む物品であつて農林水産省令で定めるものを消毒しなければならない。
- 第1項の設備が設置されている同項の施設の敷地に車両を入れる者は、農林水産省令の定めるところにより、あらかじめ、当該設備を利用して、当該車両を消毒しなければならない。

 地域社会や同業や自社への対応
地域社会や同業や自社への対応
消毒装置は、法律による設置義務以外にも、地域社会や同業への対応という観点や、自社の経営危機の回避のためにも消毒装置を設置する必要性があると言えます。
周辺地域の住民を守る!
家畜(牛、豚、鶏)から人へ感染・寄生する病原体というのがありますが、これを人獣共通感染症(zoonosis)と言っています。
人獣共通感染症の事例には、2003年12月に起きた韓国の鳥インフルエンザがあります。このインフルエンザは家畜から感染が報告されており、2004年1月にベトナムでも発生し、3例の人への感染報告されています。これを皮切りに、2004年から2005年にかけて日本、タイ、カンボジア、ラオス、インドネシア、中国、マレーシアでも流行が報告されました。
鳥インフルエンザは、2004年以来、野鳥を含めて53カ国で発生がみられており、そのうち10カ国において258例の人が感染し、内154例の死亡が報告されています。
周辺地域住民への感染を防ぐ目的でも、消毒装置の設置は必要であるといえます。
周辺地域の同業を守る!
2010年宮崎県で発生した口蹄疫ウイルスは、伝染力が強く、牛、水牛、豚、めん羊、山羊などの家畜をはじめ、野生動物を含むほとんどの偶蹄類動物が感染します。また、発病後に生じる発育障害、運動障害及び泌乳障害などによって家畜は産業動物としての価値を失い、畜産農家に甚大な被害が発生します。
感染によって被害が拡大してしまう伝染病の場合、自社だけでなく、地域の同業を守るためにも消毒装置の設置は必要であるといえます。
自社を守る!
家畜伝染病が発生した場合には、一定区域内の畜産農家は移動制限を受けたり、家畜の処分をしたりしななければならないケースがあります。
また、自社が指定区域外で、且つ自社の畜産物に影響が無かったとしても、テレビや新聞などの報道により風評被害を受けてしまうことがあります。
消毒装置を設置しておくことにより、感染病の原因となる菌やウィルスの進入を防ぐ効果が高まります。また、出入り業者や関連会社に対しては、「安全」をアピールすることにも繋がります。これにより自己防衛効果が高まり、風評被害を避けることができ、結果として自社を守ることにつながります。
以上のように車両の消毒は、地域社会や同業、自社を守り、安心安全な畜産物を作る上で重要な対策といえます
また、家畜による伝染病の広がりは、畜産農場からだけでなく、家畜市場や食肉加工センター、家畜研究施設、及びそういった場所に出入りする業者(飼料工場、買付業者など)の車両を媒介として広がりをみせることがあります。
家畜伝染病への体策は、畜産農場だけでなく、家畜に関わる業界全体での取組みが求められているといえます。

 車両消毒装置が対象とする主な病原体
車両消毒装置が対象とする主な病原体
畜産農場で問題となる主な病原体には以下のようなものが挙げられます。
| |
主な病原体 |
主な家畜の種類 |
| 1 |
牛疫 |
牛、めん羊、山羊、豚、水牛、しか、いのしし |
| 2 |
口蹄疫 |
牛、めん羊、山羊、豚、水牛、しか、いのしし |
| 3 |
流行性脳炎 |
牛、馬、めん羊、山羊、豚、水牛、しか、いのしし |
| 4 |
狂犬病 |
牛、馬、めん羊、山羊、豚、水牛、しか、いのしし |
| 5 |
水胞性口炎 |
牛、馬、豚、水牛、しか、いのしし |
| 6 |
出血性敗血症 |
牛、めん羊、山羊、豚、水牛、しか、いのしし |
| 7 |
ブルセラ病 |
牛、めん羊、山羊、豚、水牛、しか、いのしし |
| 8 |
結核病 |
牛、山羊、水牛、しか |
| 9 |
ヨーネ病 |
牛、めん羊、山羊、水牛、しか |
| 10 |
ピロプラズマ病 |
牛、馬、水牛、しか |
| 11 |
アナプラズマ病 |
牛、水牛、しか |
| 12 |
伝達性海綿状脳症(BSE) |
牛、めん羊、山羊、水牛、しか |
| 13 |
豚コレラ |
豚、いのしし |
| 14 |
鳥インフルエンザ |
鶏、あひる、うずら、きじ、だちょう、ほろほろ鳥、七面鳥 |
当社ではお客様のご使用になる薬剤を選ばず、希釈方法や倍率、撹拌機の提案など、様々なアドバイスを行っています。
バイエル薬品(株)製アンテックビルコンS、三生製薬(株)パコマ、日本製薬(株 )オスバン、 MeijiSeikaファルマ(株)クレンテ・アストップ 他 ご要望にお応えします。
![]()
![]()
消毒装置は、法律による設置義務以外にも、地域社会や同業への対応という観点や、自社の経営危機の回避のためにも消毒装置を設置する必要性があると言えます。
周辺地域の住民を守る!
家畜(牛、豚、鶏)から人へ感染・寄生する病原体というのがありますが、これを人獣共通感染症(zoonosis)と言っています。
人獣共通感染症の事例には、2003年12月に起きた韓国の鳥インフルエンザがあります。このインフルエンザは家畜から感染が報告されており、2004年1月にベトナムでも発生し、3例の人への感染報告されています。これを皮切りに、2004年から2005年にかけて日本、タイ、カンボジア、ラオス、インドネシア、中国、マレーシアでも流行が報告されました。
鳥インフルエンザは、2004年以来、野鳥を含めて53カ国で発生がみられており、そのうち10カ国において258例の人が感染し、内154例の死亡が報告されています。
周辺地域住民への感染を防ぐ目的でも、消毒装置の設置は必要であるといえます。
周辺地域の同業を守る!
2010年宮崎県で発生した口蹄疫ウイルスは、伝染力が強く、牛、水牛、豚、めん羊、山羊などの家畜をはじめ、野生動物を含むほとんどの偶蹄類動物が感染します。また、発病後に生じる発育障害、運動障害及び泌乳障害などによって家畜は産業動物としての価値を失い、畜産農家に甚大な被害が発生します。
感染によって被害が拡大してしまう伝染病の場合、自社だけでなく、地域の同業を守るためにも消毒装置の設置は必要であるといえます。
自社を守る!
家畜伝染病が発生した場合には、一定区域内の畜産農家は移動制限を受けたり、家畜の処分をしたりしななければならないケースがあります。
また、自社が指定区域外で、且つ自社の畜産物に影響が無かったとしても、テレビや新聞などの報道により風評被害を受けてしまうことがあります。
消毒装置を設置しておくことにより、感染病の原因となる菌やウィルスの進入を防ぐ効果が高まります。また、出入り業者や関連会社に対しては、「安全」をアピールすることにも繋がります。これにより自己防衛効果が高まり、風評被害を避けることができ、結果として自社を守ることにつながります。
以上のように車両の消毒は、地域社会や同業、自社を守り、安心安全な畜産物を作る上で重要な対策といえます
また、家畜による伝染病の広がりは、畜産農場からだけでなく、家畜市場や食肉加工センター、家畜研究施設、及びそういった場所に出入りする業者(飼料工場、買付業者など)の車両を媒介として広がりをみせることがあります。
家畜伝染病への体策は、畜産農場だけでなく、家畜に関わる業界全体での取組みが求められているといえます。